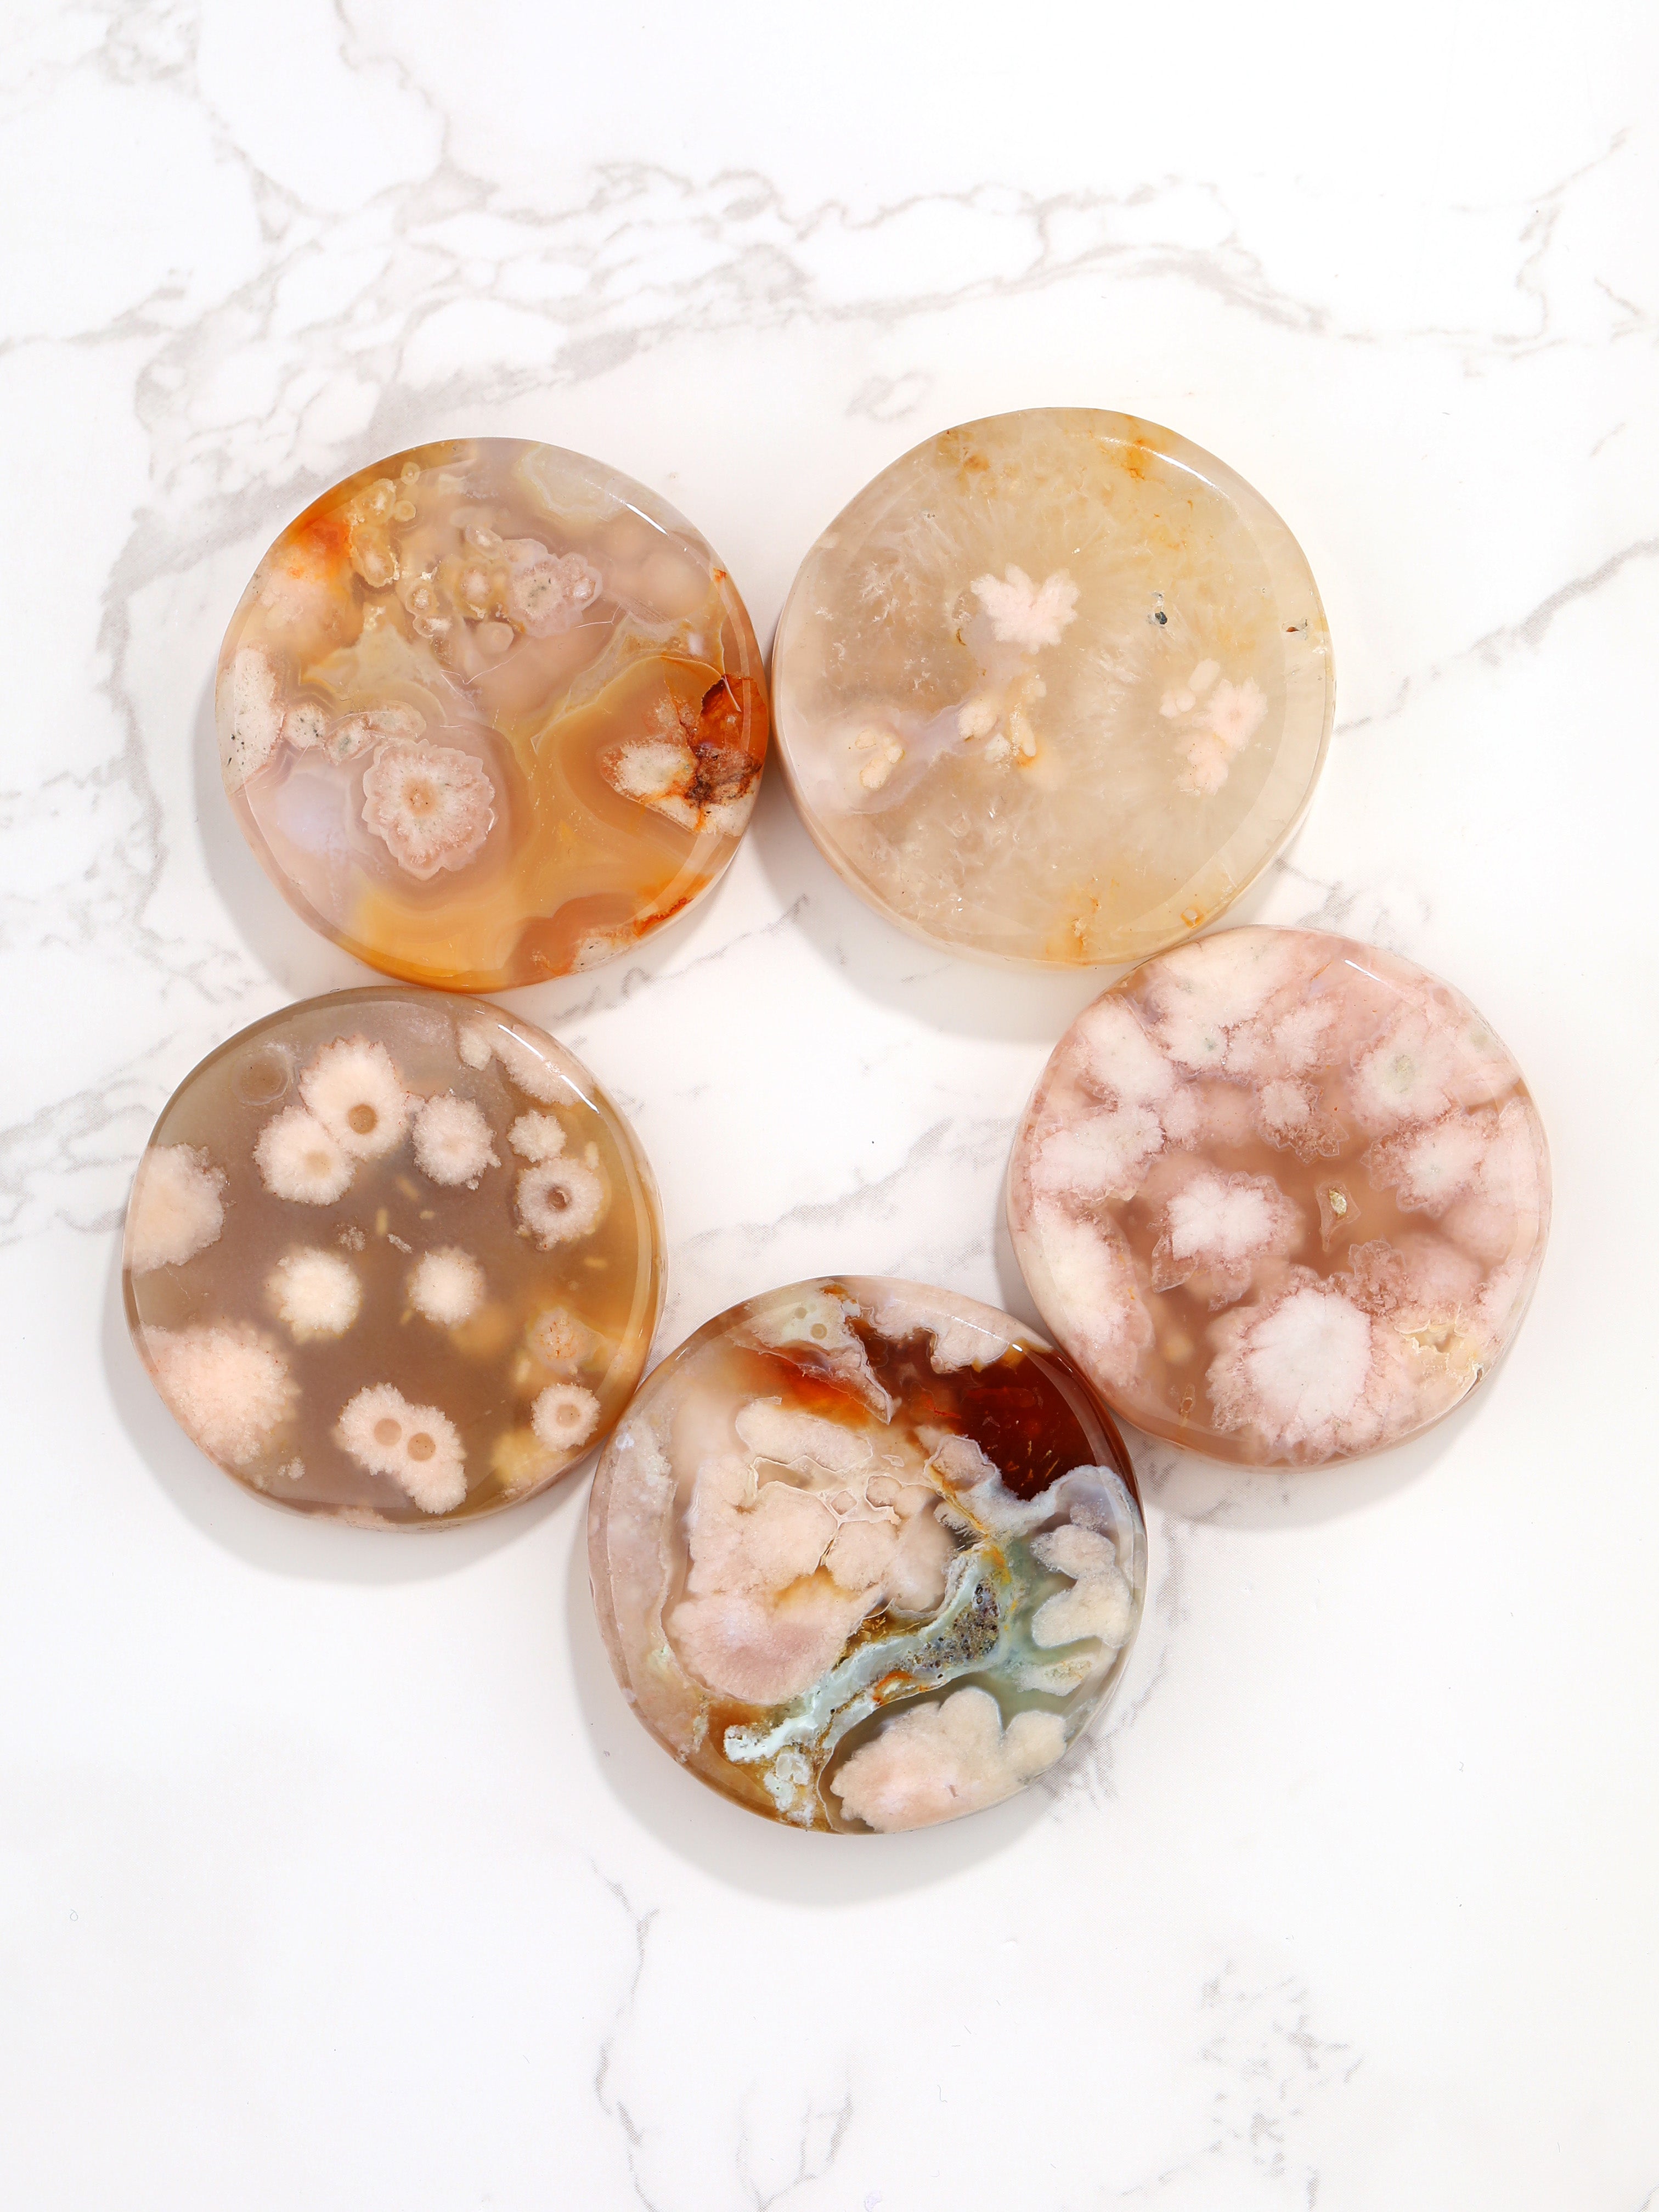
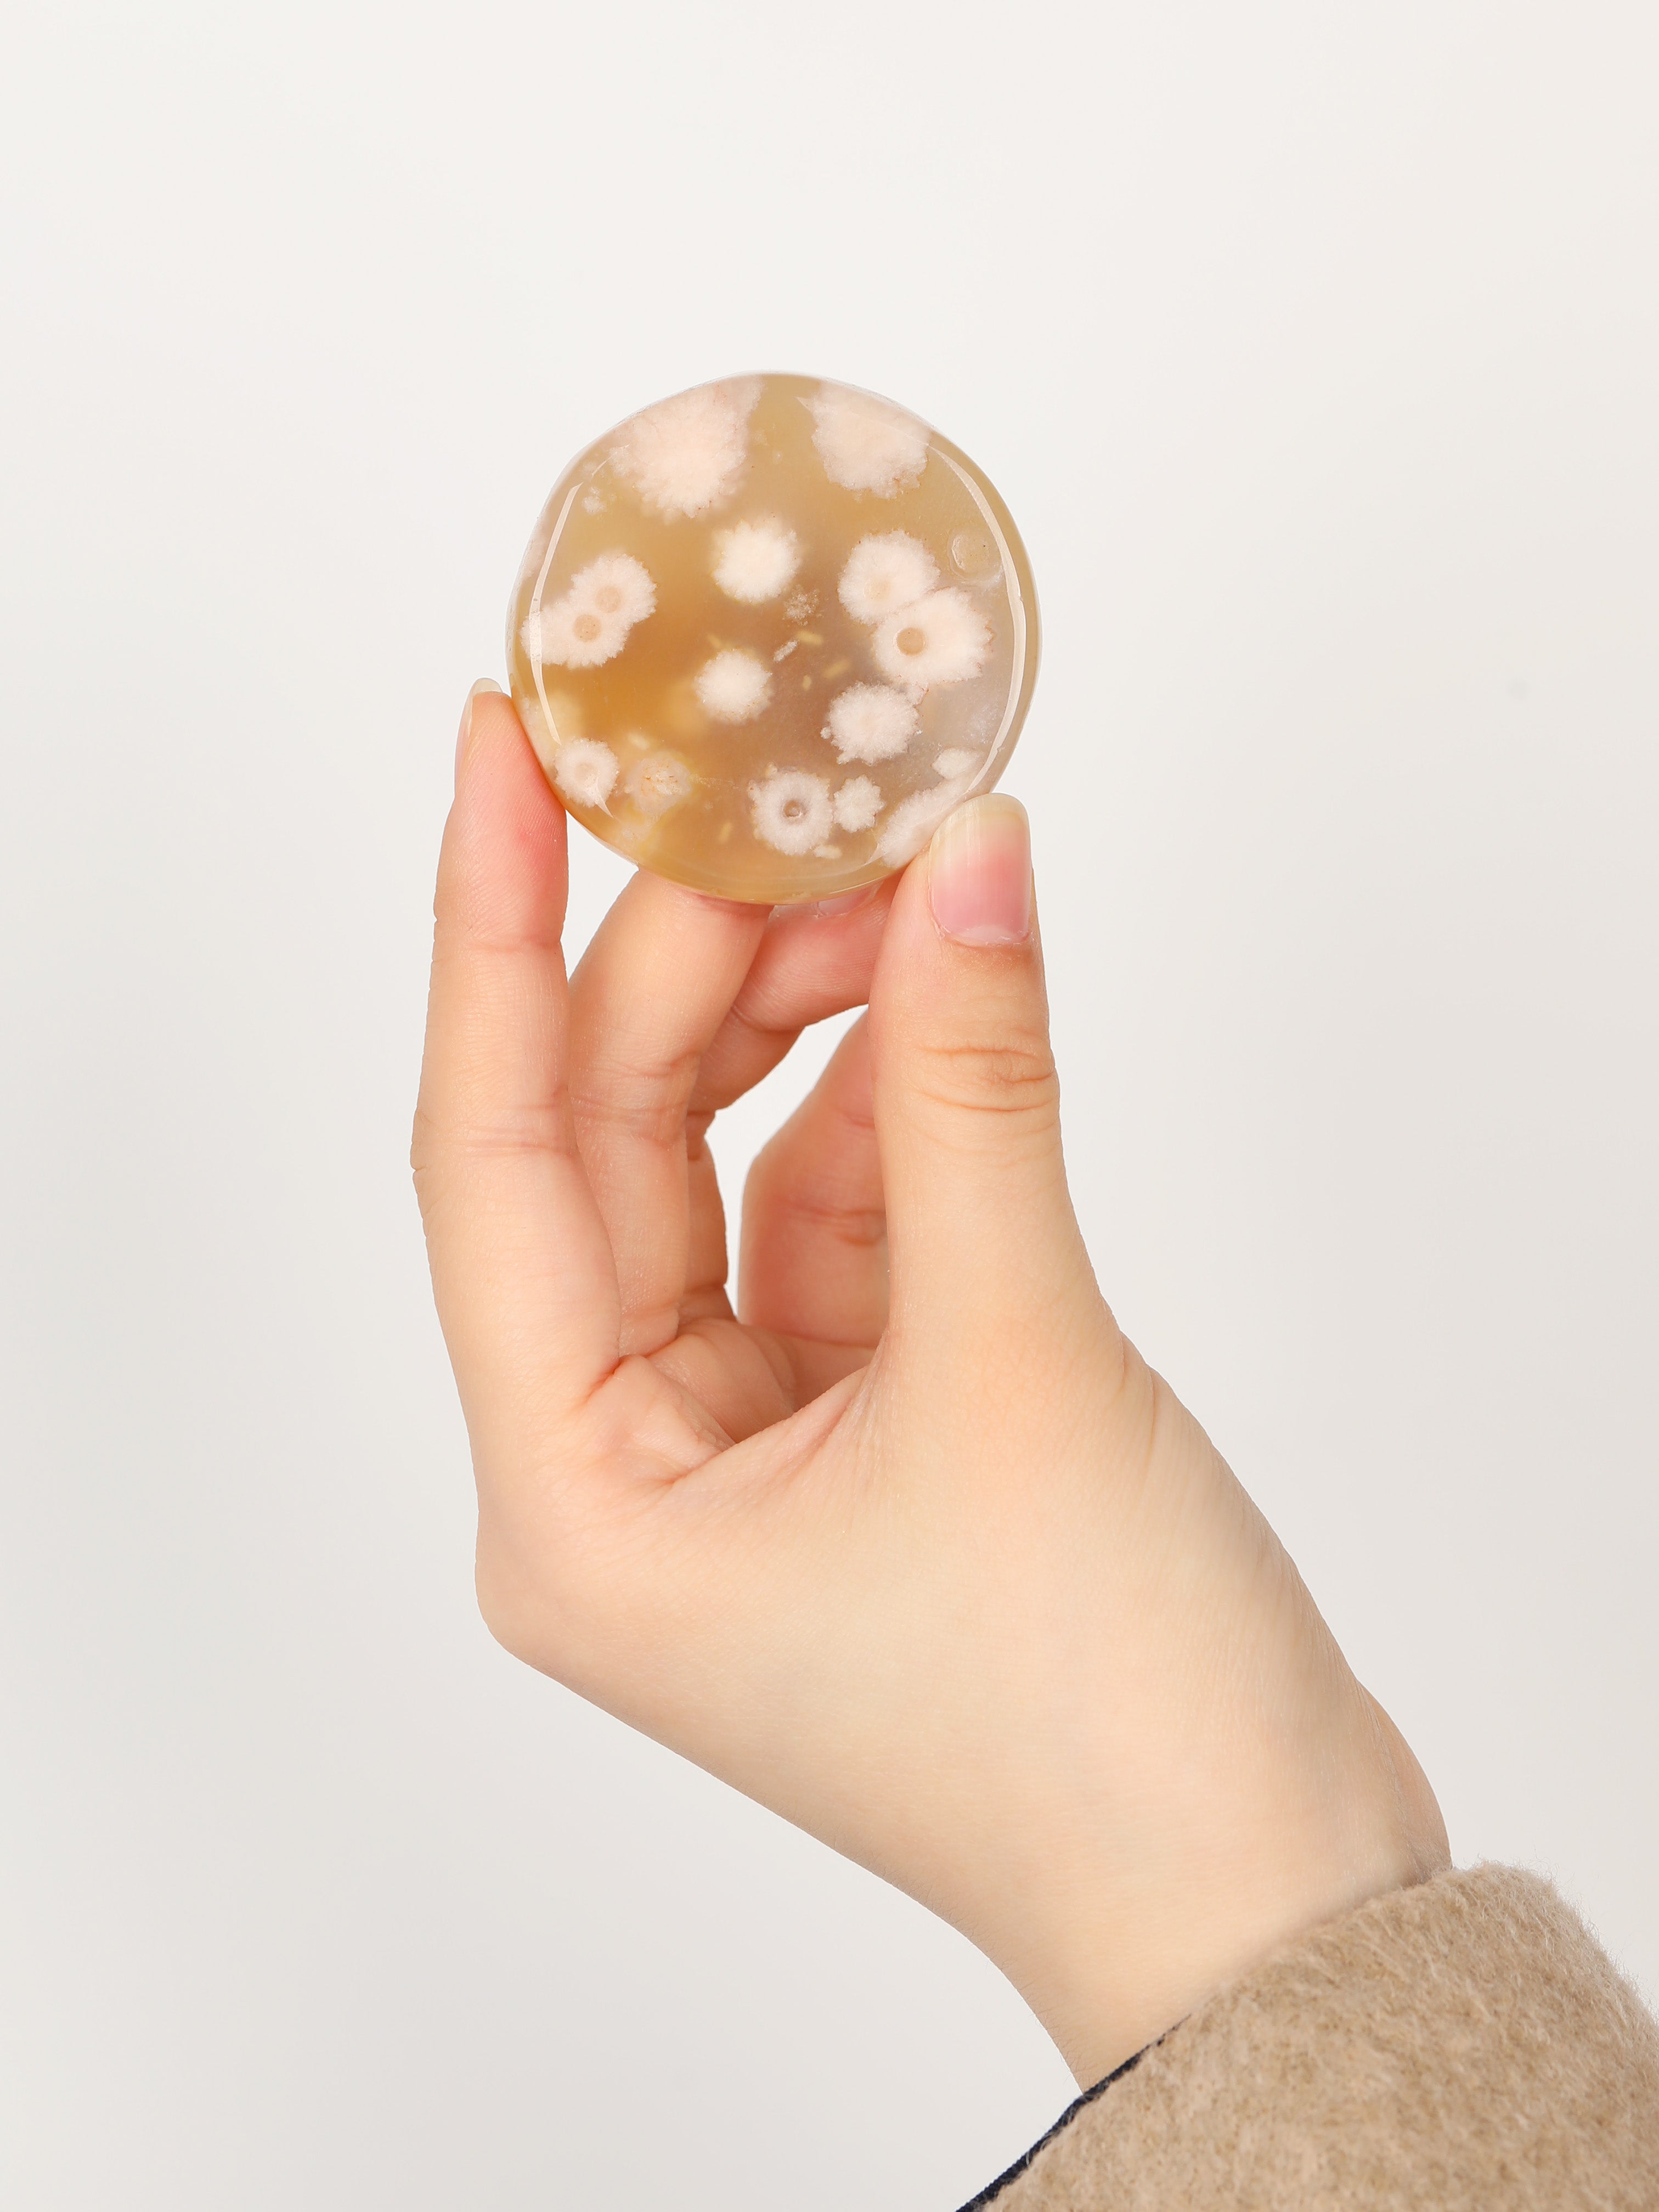

Sold Out
Cherry blossom agate stone(Random decorative pattern)
2
sold in last
8
hours
$8.00
Enhances mental function, improves concentration, enhances perception and analytical abilities.

it is a soothing calming gemstone that heals inner anger, anxiety and helps in the strengthening of relationships.

Subcribe to back in stock notification
customers are viewing this product